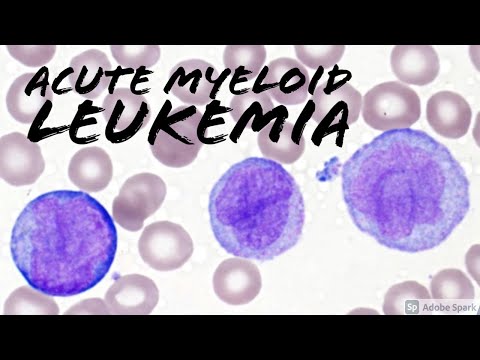

The peripheral blood film examination is a very vital diagnostic tool even today and detection of abnormal lymphocytes in the peripheral blood smears may contribute to a quick diagnosis or at least help decide on the next line of investigations. There are various terminologies that are used for abnormal-looking lymphocytes which can be very confusing and misleading. When reporting such cells an attempt should be made to differentiate between reactive and neoplastic etiologies. This case series online presentation by Dr. Pankhi Dutta during #CUBEHDMI 2023 organized by BLK-Max Hospital and Mindray India will showcase some commonly seen and some 'not so commonly seen' atypical lymphoid in the peripheral blood. For any support, please contact Mindray India using the below information: Toll-free: 0008-00-85-22-009 WhatsApp: +91 93195982909 Email: @ Website: Share, Support, Subscribe!!! YouTube: @mindray_india Facebook: Linkedin: Twitter: Instagram: #mindray #MindrayIndia @drpankhidutta326 @BLKSuperSpecialityHospital @ahhemat @MindrayInternational @mindray_india